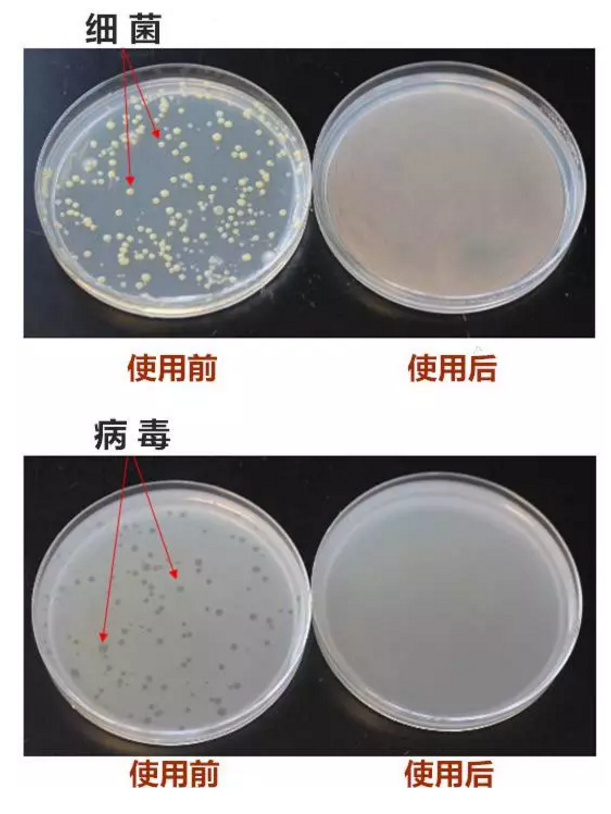
6.png

七芯好水,金伟连净水机带给您

净水杀菌
海罗净解决有道
五号滤芯海罗净,是一种新型高效杀菌滤芯,它源自美国的专利技术,有效杀死细菌和病毒,确保无细菌二次污染。
你所知道的海罗净杀菌滤芯仅仅只是这样吗?

NO!NO!NO!
海罗净杀菌滤芯,
远比你想象中更强大!

海罗净杀菌滤芯
一种彻底、持久和有效的杀菌技术
杀灭细菌和病毒,
无需使用电力,
经济环保
杀死病毒和细菌,确保饮用水健康
脊髓灰质炎(小儿麻痹)大肠杆菌,轮状病毒(导致严重腹泻)
微囊藻毒素(由于饮水污染引起的肝癌发病率,使癌症的发生可能性提高近10倍)
印度超级细菌容易产生变异病毒,导致流行病的发生。
控制生物膜病毒(黏在自来水管道或是饮水设备上绿色或手摸粘性的物质)
对口感无影响
对水管下游管道通路和水容器可持续抑制细菌滋生,避免二次污染
易于安装和更换

实际效果看得到!
以上功能,海罗净杀菌滤芯是怎样轻松实现的呢?小小的身材却拥有大大的能量!
技术原理
海罗净杀菌技术采用溴原子与惰性高分子结合的技术,细菌或病毒只要接触了海罗净滤芯,几秒钟内即被杀灭。





海罗净杀菌效果
实验室数据图表

实验表明
在使用海罗净滤芯一年的寿命周期内,可以实现杀菌/病毒,同时确保持续杀菌/杀菌的效果稳定。
数据显示,大肠杆菌和噬菌体病毒的数量可以减少到99.9%。
权威认证 净水到家 健康全家
一个由众多化学、微生物学及工程学领域内的博士、硕士组成的科研团队,历经十几年研发成“海罗净”材料,并获得美国最严格卫生安全组织—美国环保署(EPA)和国家卫生基金会(NSF)的许可,以及一系列的认证和检测:





关于海罗净,
听听杰夫博士怎么说
七芯好水带回家,
为了回馈广大顾客,
从2017年7月起
公司推出双重优惠活动:




